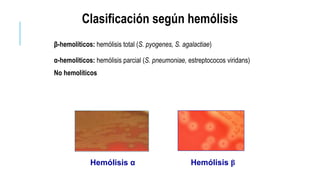
β-hemolíticos: hemólisis total (S. pyogenes, S. agalactiae)
α-hemoliticos: hemólisis parcial (S. pneumoniae, estreptococos viridans)
No hemolíticos
Hemólisis α Hemólisis β
Clasificación según hemólisis

El documento proporciona información sobre Streptococcus. Describe que son cocos gram positivos que forman cadenas y son anaerobios facultativos. Se clasifican según su patrón hemolítico (α, β, γ), y grupos como Streptococcus pyogenes y Streptococcus agalactiae causan enfermedades como faringitis, fascitis necrosante y sepsis neonatal. El documento también explica métodos de diagnóstico e importancia de la prevención y tratamiento con antibióticos.

![La enfermedad en los niños menores
de 7 días se denomina enfermedad de
comienzo precoz, mientras que la que
aparece entre la primera semana y los
3 meses de vida se considera
enfermedad de comienzo tardío.
• comienzo precoz son los serotipos la [35-40% ], III
(30% ) y V (15% ).
• serotipos la y V son los más habituales en la
enfermedad del adulto
• serotipo III se aísla en la mayoría de los casos de
enfermedad de comienzo tardío.](https://image.slidesharecdn.com/streptococcus-170430170332/85/Streptococcus-gabriela-seanez-46-320.jpg)















![Coco Gram Positivo
Encapsulado
diámetro de 0 ,5 a 1,2 um, con forma ovalada
se disponen en parejas (diplococos] o en cadenas cortas.
Las colonias de las cepas
encapsuladas suelen ser grandes
(1 a 3 mm de diámetro en agar
sangre; más pequeñas en agar
chocolate o medios con sangre
calentada), redondas y mucoides.](https://image.slidesharecdn.com/streptococcus-170430170332/85/Streptococcus-gabriela-seanez-62-320.jpg)
























